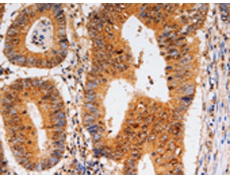
一抗

中文名稱:兔抗CDK6多克隆抗體
英文名稱: Anti-CDK6 rabbit polyclonal antibody
別 名: PLSTIRE
相關(guān)類別: 一抗
儲(chǔ) 存: 冷凍(-20℃)
宿 主: Rabbit
抗 原: CDK6
反應(yīng)種屬: Human, Mouse
標(biāo) 記 物: Unconjugate
克隆類型: rabbit polyclonal
技術(shù)規(guī)格
|
Background: |
The protein encoded by this gene is a member of the cyclin-dependent protein kinase (CDK) family. CDK family members are highly similar to the gene products of Saccharomyces cerevisiae cdc28, and Schizosaccharomyces pombe cdc2, and are known to be important regulators of cell cycle progression. This kinase is a catalytic subunit of the protein kinase complex that is important for cell cycle G1 phase progression and G1/S transition. The activity of this kinase first appears in mid-G1 phase, which is controlled by the regulatory subunits including D-type cyclins and members of INK4 family of CDK inhibitors. This kinase, as well as CDK4, has been shown to phosphorylate, and thus regulate the activity of, tumor suppressor protein Rb. Expression of this gene is up-regulated in some types of cancer. Multiple alternatively spliced variants, encoding the same protein, have been identified. |
|
Applications: |
ELISA, WB, IHC |
|
Name of antibody: |
CDK6 |
|
Immunogen: |
Fusion protein of human CDK6 |
|
Full name: |
Cyclin-dependent kinase 6 |
|
Synonyms: |
PLSTIRE |
|
SwissProt: |
Q00534 |
|
ELISA Recommended dilution: |
1000-5000 |
|
IHC positive control: |
Human colon cancer |
|
IHC Recommend dilution: |
10-50 |
|
WB Predicted band size: |
37 kDa |
|
WB Positive control: |
Jurkat cells |
|
WB Recommended dilution: |
500-2000 |


 購(gòu)物車
購(gòu)物車 幫助
幫助
 021-54845833/15800441009
021-54845833/15800441009